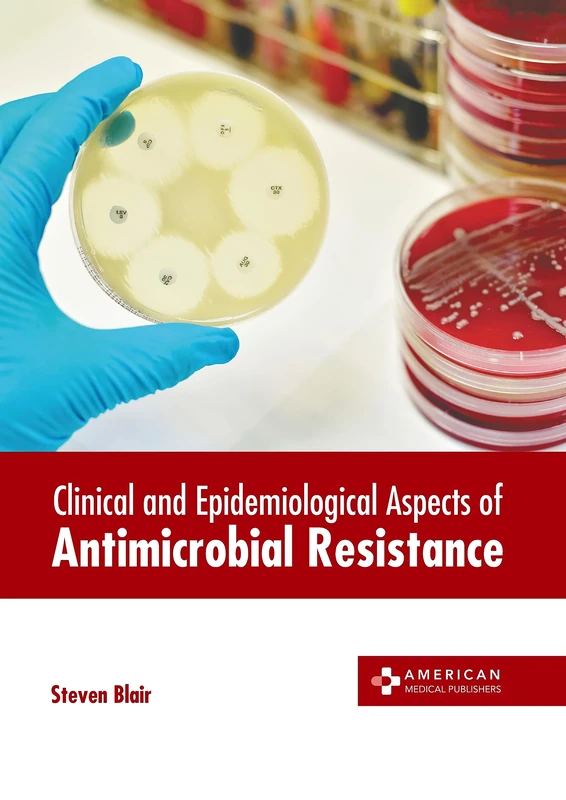
Clinical and Epidemiological Aspects of Antimicrobial Resistance
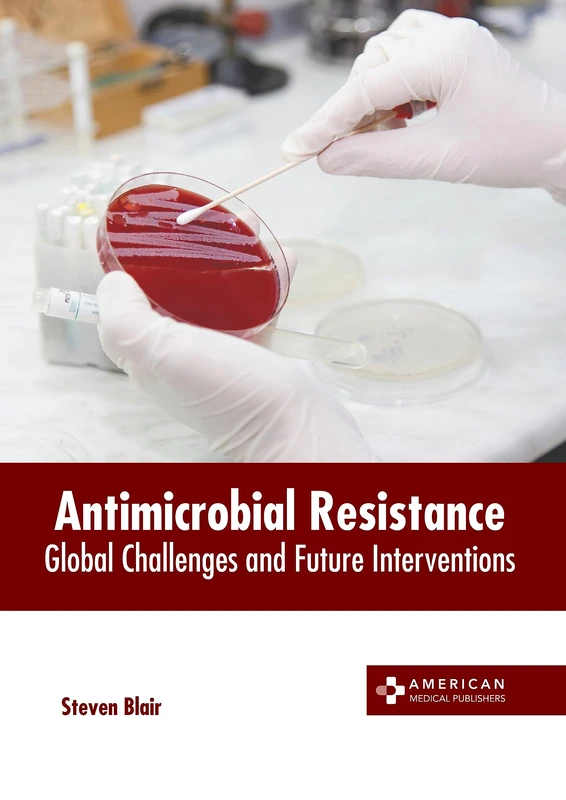
Antimicrobial Resistance: Global Challenges and Future Interventions

We can't find the internet
Attempting to reconnect
Something went wrong!
Hang in there while we get back on track

£175.14
Antibiotic Resistance: Causes & Risk Factors, Mechanisms & Alternatives (Pharmacology Research, Safety Testing and Regulation Series)
Price data last checked 131 day(s) ago - refreshing...
We'll watch every seller, every day. One email when your price arrives.
This is the most expensive it has ever been. Walk away.
£175 today · previous high £175 · all-time low £8
NEW HERE?
Amazon shows you one price. We show you all of them.
Tosheroon watches Amazon prices so you don't have to. Every product on Amazon has a price history — we make it visible. Set the price you'd actually pay, and we'll email you the second it gets there. No app, no account, one email.
WHAT'S ON THIS PAGE
when this has been cheap or pricey
where the price is heading next
all-time high & low, recent range
name your number, we'll email you
Price History & Forecast
Grey patches = out of stock. Cheaper = lower on the chart. Hover for exact prices.
Last 600 days • 600 data points (No recent data available)
Price Distribution
Price distribution over 600 days • 5 price ranges
Price Analysis
Most common range: £41-75 (305 days, 50.8%)
Price range: £7.71 - £175
Price levels: 5 price ranges over 600 days
Description
Key Features
New
Mint Condition
Dispatch same day for order received before 12 noon
Guaranteed packaging
No quibbles returns
Product Specifications
- Format
- hardcover
- ASIN
- 1607416239
- Domain
- Amazon UK
- Release Date
- 01 October 2009
- Listed Since
- 08 May 2009
Barcode
No barcode data available
Similar Products You Might Like

Antibiotic Resistance: Origins, Evolution, Selection and Spread: No.207 (Novartis Foundation Symposia)
Wiley-Blackwell
Clinical and Epidemiological Aspects of Antimicrobial Resistance
Antimicrobial Resistance: Global Challenges and Future Interventions

Bacterial Resistance to Antimicrobials
CRC Press

Bacterial Resistance to Antimicrobials
CRC Press

Antibiotic Resistance: 211 (Handbook of Experimental Pharmacology, 211)
Springer

The Ongoing Challenge of Antimicrobial Resistance, An Issue of Infectious Disease Clinics of North America: Volume 34-4 (The Clinics: Internal Medicine, Volume 34-4)
Elsevier

Antibiotic Resistance: 211 (Handbook of Experimental Pharmacology, 211)
Springer

Antimicrobial Drug Resistance: Clinical and Epidemiological Aspects, Volume 2
Springer

Antimicrobial Resistance: Collaborative Measures of Control
CRC Press

Antimicrobial Drug Resistance: Mechanisms of Drug Resistance, Volume 1
Springer

Antimicrobial Resistance in the Environment
Wiley-Blackwell

Antibiotics and Antibiotic Resistance in the Environment
CRC Press

Antimicrobial Resistance and Implications for the 21st Century (Emerging Infectious Diseases of the 21st Century)
Springer

Antibiotic Resistance: Challenges and Opportunities, An Issue of Infectious Disease Clinics of North America (Volume 30-2) (The Clinics: Internal Medicine, Volume 30-2)
Elsevier

Antimicrobial Resistance and Infection Control
Foster Academics

Antibiotics - Therapeutic Spectrum and Limitations (Developments in Microbiology)

The Global Antimicrobial Resistance Epidemic - Innovative Approaches and Cutting-Edge Solutions
IntechOpen

Antimicrobial Resistance: Underlying Mechanisms and Therapeutic Approaches

Antimicrobial Drug Resistance: Clinical and Epidemiological Aspects, Volume 2 (Infectious Disease)
Humana

Antimicrobial Resistance: Underlying Mechanisms and Therapeutic Approaches
Springer

21st Century Challenges in Antimicrobial Therapy and Stewardship (Frontiers in Anti-Infective Agents)

Antibiotic Resistance: Mechanisms and New Antimicrobial Approaches
Academic Press
